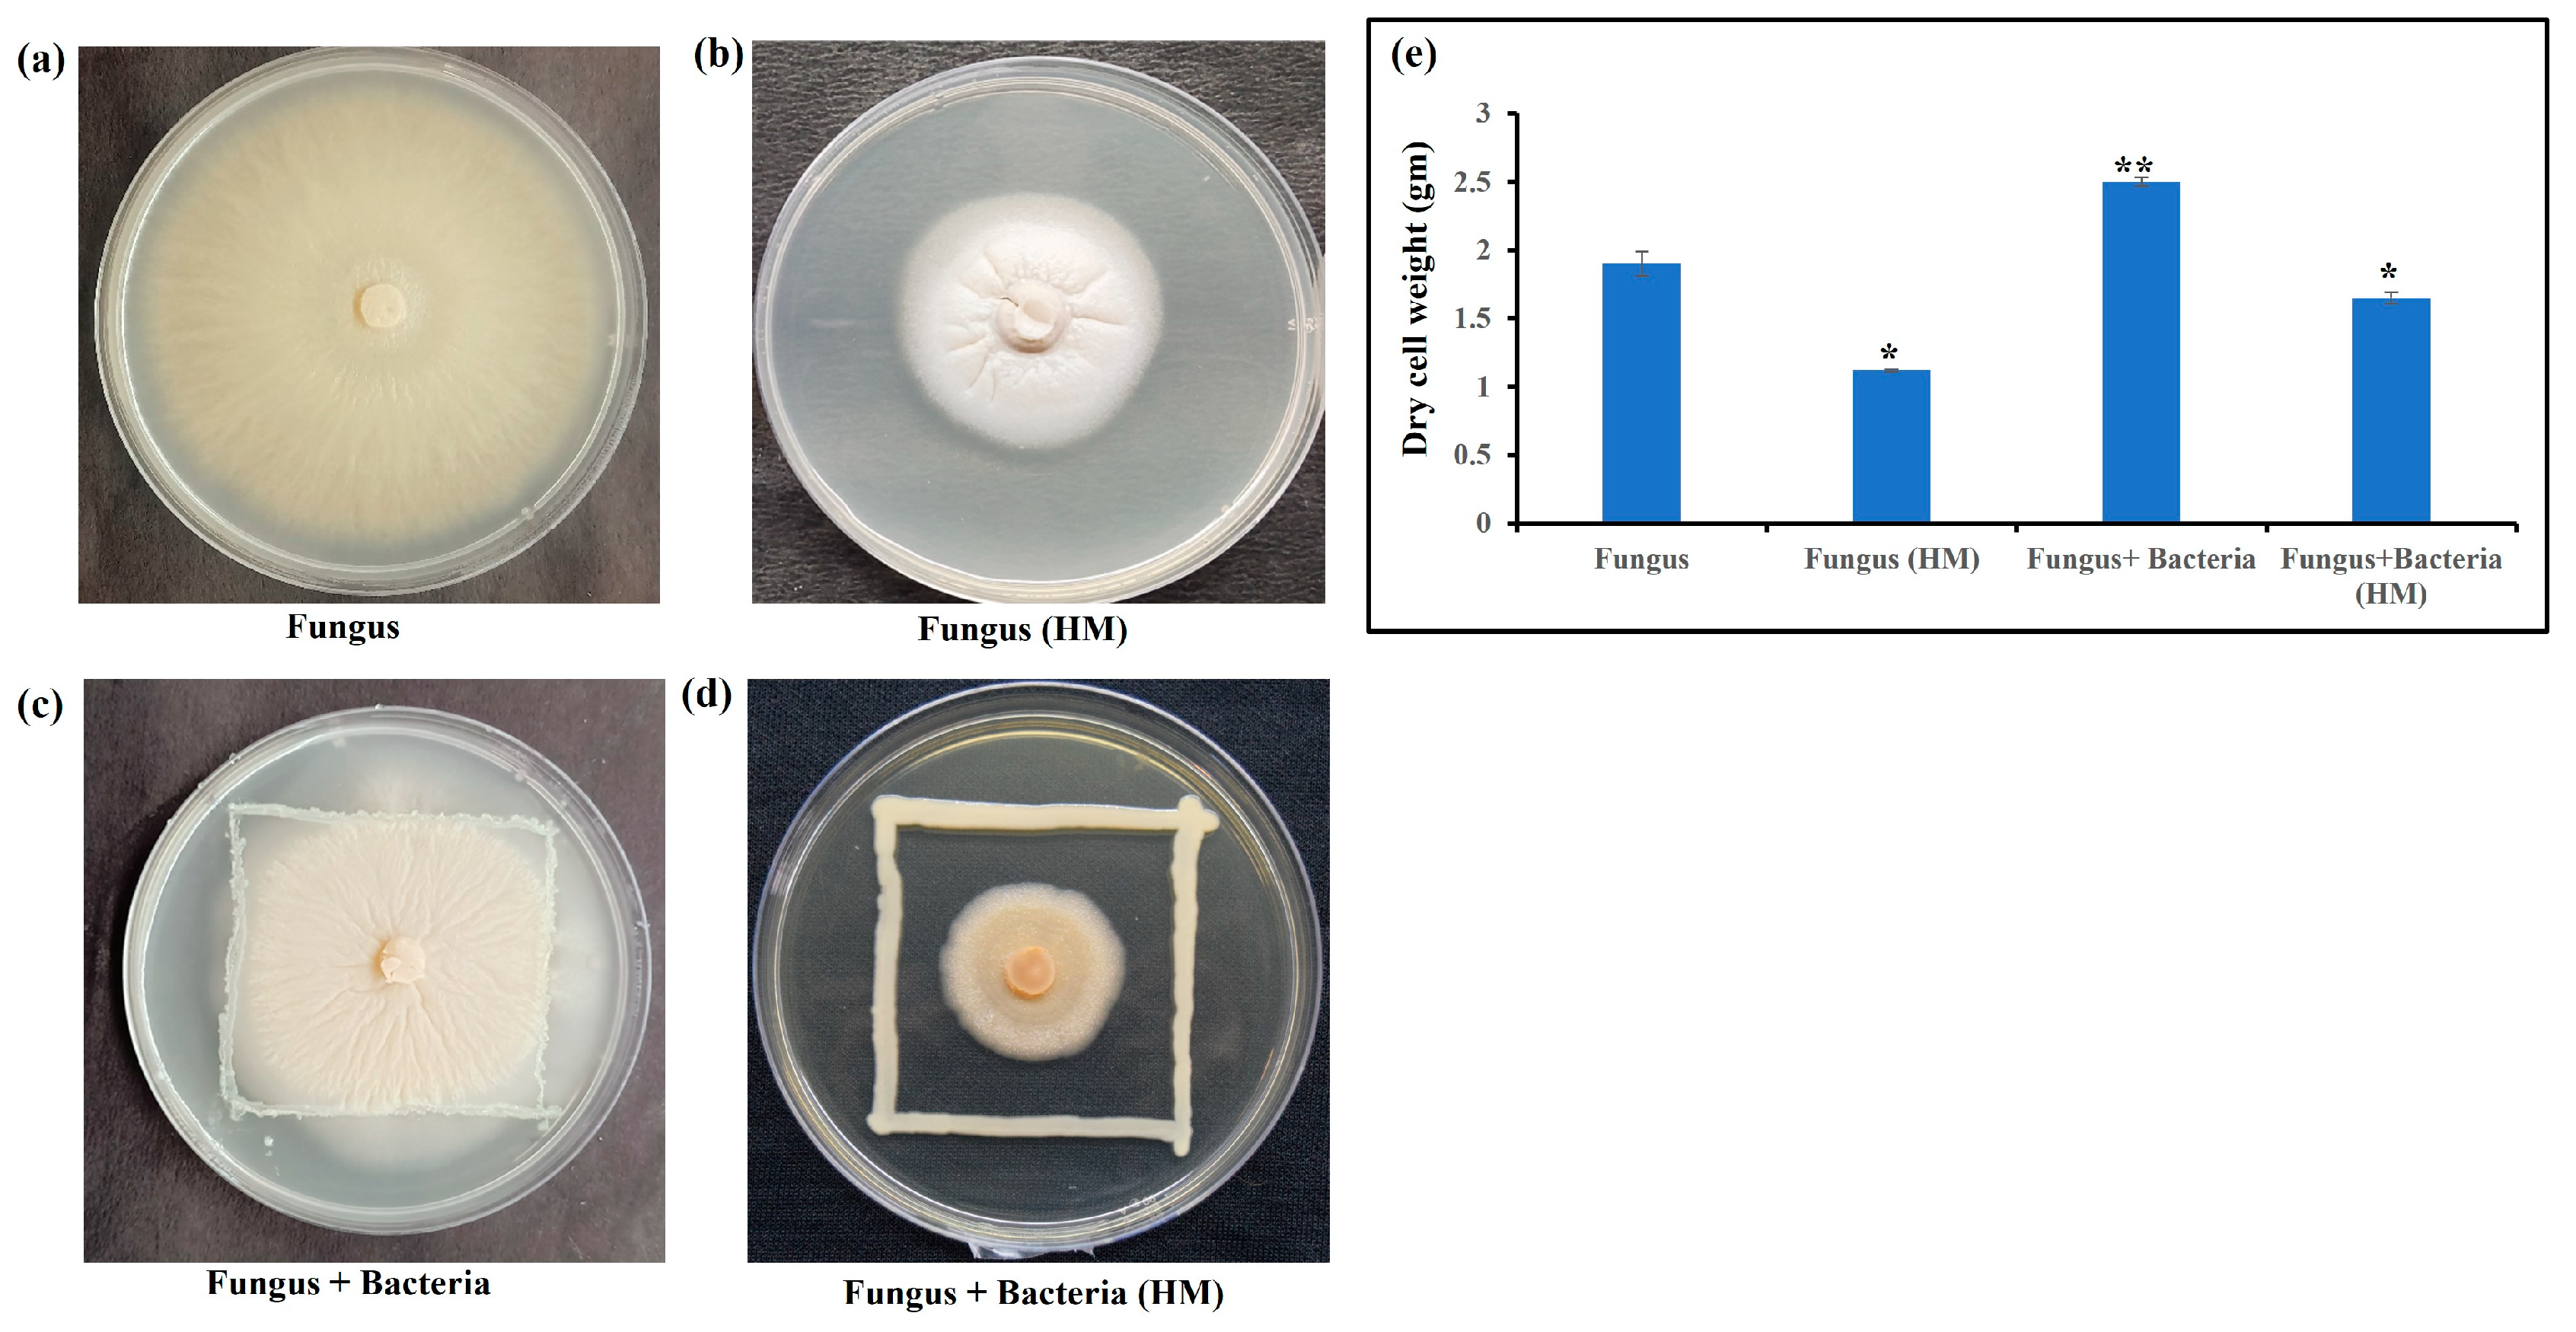

Fungal-Bacterial Combinations in Plant Health under Stress: Physiological and Biochemical Characteristics of the Filamentous Fungus Serendipita indica and the Actinobacterium Zhihengliuella sp. ISTPL4 under In Vitro Arsenic Stress
Abstract
1. Introduction
2. Materials and Methods
2.1. Microbe Culture and Conditions
2.2. Effect of Arsenic on Fungal Growth
2.3. Spore Morphology
2.4. Biotransformation of Arsenic
2.5. Gas Chromatography and Mass Spectroscopy Analysis (GC-MS)
2.6. Clustered Heatmap of Metabolites
2.7. Statistical Method
3. Results
3.1. Microbial Conditions
3.2. Spore Morphology
3.3. Biotransformation of Arsenic
3.4. Production of Secondary Metabolites
4. Discussion
5. Conclusions
Supplementary Materials
Author Contributions
Funding
Data Availability Statement
Acknowledgments
Conflicts of Interest
References
- Zaman, N.R.; Chowdhury, U.F.; Reza, R.N.; Chowdhury, F.T.; Sarker, M.; Hossain, M.M.; Akbor, M.A.; Amin, A.; Islam, M.R.; Khan, H. Plant Growth Promoting Endophyte Burkholderia Contaminans NZ Antagonizes Phytopathogen Macrophomina Phaseolina through Melanin Synthesis and Pyrrolnitrin Inhibition. PLoS ONE 2021, 16, e0257863. [Google Scholar] [CrossRef] [PubMed]
- Genchi, G.; Lauria, G.; Catalano, A.; Carocci, A.; Sinicropi, M.S. Arsenic: A Review on a Great Health Issue Worldwide. Appl. Sci. 2022, 12, 6184. [Google Scholar] [CrossRef]
- Bianucci, E.; Peralta, J.M.; Furlan, A.; Hernández, L.E. Arsenic in Drinking Water and Food; Springer: Berlin/Heidelberg, Germany, 2020. [Google Scholar] [CrossRef]
- Chandrakar, V.; Pandey, N.; Keshavkant, S. Plant Responses to Arsenic Toxicity: Morphology and Physiology. In Mechanisms of Arsenic Toxicity and Tolerance in Plants; Springer: Singapore, 2018. [Google Scholar]
- Pérez-Montaño, F.; Alías-Villegas, C.; Bellogín, R.A.; Del Cerro, P.; Espuny, M.R.; Jiménez-Guerrero, I.; López-Baena, F.J.; Ollero, F.J.; Cubo, T. Plant Growth Promotion in Cereal and Leguminous Agricultural Important Plants: From Microorganism Capacities to Crop Production. Microbiol. Res. 2014, 169, 325–336. [Google Scholar] [CrossRef] [PubMed]
- Mitra, D.; Mondal, R.; Khoshru, B.; Senapati, A.; Radha, T.K.; Mahakur, B.; Uniyal, N.; Myo, E.M.; Boutaj, H.; Sierra, B.E.G.; et al. Actinobacteria-Enhanced Plant Growth, Nutrient Acquisition, and Crop Protection: Advances in Soil, Plant, and Microbial Multifactorial Interactions. Pedosphere 2022, 32, 149–170. [Google Scholar] [CrossRef]
- Koza, N.A.; Adedayo, A.A.; Babalola, O.O.; Kappo, A.P. Microorganisms in Plant Growth and Development: Roles in Abiotic Stress Tolerance and Secondary Metabolites Secretion. Microorganisms 2022, 10, 1528. [Google Scholar] [CrossRef]
- Pang, Z.; Chen, J.; Wang, T.; Gao, C.; Li, Z.; Guo, L.; Xu, J.; Cheng, Y. Linking Plant Secondary Metabolites and Plant Microbiomes: A Review. Front. Plant Sci. 2021, 12, 621276. [Google Scholar] [CrossRef]
- Barra Caracciolo, A.; Terenzi, V. Rhizosphere Microbial Communities and Heavy Metals. Microorganisms 2021, 9, 1462. [Google Scholar] [CrossRef]
- Raychaudhuri, S.S.; Pramanick, P.; Talukder, P.; Basak, A. Polyamines, Metallothioneins, and Phytochelatins—Natural Defense of Plants to Mitigate Heavy Metals. Stud. Nat. Prod. Chem. 2021, 69, 227–261. [Google Scholar]
- Varma, A.; Sowjanya Sree, K.; Arora, M.; Bajaj, R.; Prasad, R.; Kharkwal, A.C. Functions of Novel Symbiotic Fungus—Piriformospora indica. Proc. Indian Natl. Sci. Acad. 2014, 80, 429–441. [Google Scholar] [CrossRef]
- Jangir, P.; Shekhawat, P.K.; Bishnoi, A.; Ram, H.; Soni, P. Role of Serendipita indica in Enhancing Drought Tolerance in Crops. Physiol. Mol. Plant Pathol. 2021, 116, 101691. [Google Scholar] [CrossRef]
- Yang, G.; Ahmad, F.; Zhou, Q.; Guo, M.; Liang, S.; Gaal, H.A.; Mo, J. Investigation of Physicochemical Indices and Microbial Communities in Termite Fungus-Combs. Front. Microbiol. 2021, 11, 581219. [Google Scholar] [CrossRef] [PubMed]
- Sharma, N.; Dabral, S.; Tyagi, J.; Yadav, G.; Aggarwal, H.; Joshi, N.C.; Varma, A.; Koul, M.; Choudhary, D.K.; Mishra, A. Interaction Studies of Serendipita indica and Zhihengliuella sp. ISTPL4 and Their Synergistic Role in Growth Promotion in Rice. Front. Plant Sci. 2023, 14, 1155715. [Google Scholar] [CrossRef] [PubMed]
- Hill, T.W.; Kafer, E. Improved Protocols for Aspergillus minimal Medium: Trace Element and Minimal Medium Salt Stock Solutions. Fungal Genet. Rep. 2001, 48, 20–21. [Google Scholar] [CrossRef]
- Mohd, S.; Shukla, J.; Kushwaha, A.S.; Mandrah, K.; Shankar, J.; Arjaria, N.; Saxena, P.N.; Narayan, R.; Roy, S.K.; Kumar, M. Endophytic Fungi Piriformospora indica Mediated Protection of Host from Arsenic Toxicity. Front. Microbiol. 2017, 8, 754. [Google Scholar] [CrossRef]
- Dabral, S.; Saxena, S.C.; Choudhary, D.K.; Bandyopadhyay, P.; Sahoo, R.K.; Tuteja, N.; Nath, M. Synergistic Inoculation of Azotobacter Vinelandii and Serendipita indica Augmented Rice Growth. Symbiosis 2020, 81, 139–148. [Google Scholar] [CrossRef]
- Bhati, R.; Sreedharan, S.M.; Rizvi, A.; Khan, M.S.; Singh, R. An Insight into Efflux-Mediated Arsenic Resistance and Biotransformation Potential of Enterobacter cloacae RSC3 from Arsenic Polluted Area. Indian J. Microbiol. 2022, 62, 456–467. [Google Scholar] [CrossRef]
- Gengmao, Z.; Quanmei, S.; Yu, H.; Shihui, L.; Changhai, W. The Physiological and Biochemical Responses of a Medicinal Plant (Salvia miltiorrhiza L.) to Stress Caused by Various Concentrations of NaCl. PLoS ONE 2014, 9, e89624. [Google Scholar] [CrossRef] [PubMed]
- Tripathi, A.; Singh, Y.; Verma, D.K.; Ranjan, M.R.; Srivastava, S.K. Bioremediation of Hazardous Azo Dye Methyl Red by a Newly Isolated Bacillus megaterium ITBHU01: Process Improvement through ANN-GA Based Synergistic Approach. Indian J. Biochem. Biophys. 2016, 53, 112–125. [Google Scholar]
- Anantha, P.S.; Deventhiran, M.; Saravanan, P.; Anand, D.; Rajarajan, S. A Comparative GC-MS Analysis of Bacterial Secondary Metabolites of Pseudomonas Species. Pharma Innov. 2016, 5, 84–89. [Google Scholar]
- Poveda, J.; Baptista, P.; Sacristán, S.; Velasco, P. Editorial: Beneficial Effects of Fungal Endophytes in Major Agricultural Crops. Front. Plant Sci. 2022, 13, 1061112. [Google Scholar] [CrossRef]
- Okon, O.; Matrood, A.; Okon, J. Na+ Exclusion and Na+/K+ Ratio Adjustment by Mycorrhiza Enhances Macro/Micro Nutrients Uptake in Two Members of Cucurbitaceae Family under Salt Stress. Int. J. Bot. Stud. 2020, 5, 108–114. [Google Scholar]
- Fa, A.N. Endophytic Fungi for Sustainable Agriculture. Microb. Biosyst. 2019, 4, 31–44. [Google Scholar] [CrossRef]
- Rabiey, M.; Ullah, I.; Shaw, L.J.; Shaw, M.W. Potential Ecological Effects of Piriformospora indica, a Possible Biocontrol Agent, in UK Agricultural Systems. Biol. Control 2017, 104, 1–9. [Google Scholar] [CrossRef]
- Dabral, S.; Yashaswee; Varma, A.; Choudhary, D.K.; Bahuguna, R.N.; Nath, M. Biopriming with Piriformospora indica Ameliorates Cadmium Stress in Rice by Lowering Oxidative Stress and Cell Death in Root Cells. Ecotoxicol. Environ. Saf. 2019, 186, 109741. [Google Scholar] [CrossRef] [PubMed]
- Mishra, A.; Jha, G.; Thakur, I.S. Draft Genome Sequence of Zhihengliuella sp. Strain ISTPL4, a Psychrotolerant and Halotolerant Bacterium Isolated from Pangong Lake, India. Genome Announc. 2018, 6, e01533-17. [Google Scholar] [CrossRef] [PubMed]
- Bernhard, A.E.; Sheffer, R.; Giblin, A.E.; Marton, J.M.; Roberts, B.J. Population Dynamics and Community Composition of Ammonia Oxidizers in Salt Marshes after the Deepwater Horizon Oil Spill. Front. Microbiol. 2016, 7, 854. [Google Scholar] [CrossRef]
- Vanitha, V.; Vijayakumar, S.; Nilavukkarasi, M.; Punitha, V.; Vidhya, E.; Praseetha, P. Heneicosane—A Novel Microbicidal Bioactive Alkane Identified from Plumbago Zeylanica L. Ind. Crops Prod. 2020, 154, 112748. [Google Scholar] [CrossRef]
- Wani, S.H.; Kumar, V.; Shriram, V.; Sah, S.K. Phytohormones and Their Metabolic Engineering for Abiotic Stress Tolerance in Crop Plants. Crop J. 2016, 4, 162–176. [Google Scholar] [CrossRef]
- Singh, R.; Kumar, M.; Mittal, A.; Mehta, P.K. Microbial Metabolites in Nutrition, Healthcare and Agriculture. 3 Biotech 2017, 7, 15. [Google Scholar] [CrossRef]
- Gadhi, A.A.A.; El-Sherbiny, M.M.O.; Al-Sofyani, A.M.A.; Ba-Akdah, M.A.; Satheesh, S. Antibiofilm Activities of Extracts of the Macroalga Halimeda sp. from the Red Sea. J. Mar. Sci. Technol. 2018, 26, 838–846. [Google Scholar] [CrossRef]
- Khattab, A.I.; Babiker, E.H.; Saeed, H.A. Streptomyces: Isolation, Optimization of Culture Conditions and Extraction of Secondary Metabolites. Int. Curr. Pharm. J. 2016, 5, 27–32. [Google Scholar] [CrossRef]
- Shaaban, M.T.; Ghaly, M.F.; Fahmi, S.M. Antibacterial Activities of Hexadecanoic Acid Methyl Ester and Green-Synthesized Silver Nanoparticles against Multidrug-Resistant Bacteria. J. Basic Microbiol. 2021, 61, 557–568. [Google Scholar] [CrossRef]
- Ferdosi, M.F.H.; Javaid, A.; Khan, I.H. Phytochemical Profile of N-Hexane Flower Extract of Cassia fistula L. Bangladesh J. Bot. 2022, 51, 393–399. [Google Scholar] [CrossRef]
- Chenniappan, J.; Sankaranarayanan, A.; Arjunan, S. Evaluation of Antimicrobial Activity of Cissus quadrangularis L. Stem Extracts against Avian Pathogens and Determination of Its Bioactive Constituents Using GC-MS. J. Sci. Res. 2020, 64, 90–96. [Google Scholar] [CrossRef]
- Chandrasekaran, M.; Senthilkumar, A.; Venkatesalu, V. Antibacterial and Antifungal Efficacy of Fatty Acid Methyl Esters from the Leaves of Sesuvium portulacastrum L. Eur. Rev. Med. Pharmacol. Sci. 2011, 15, 775–780. [Google Scholar]
- Naim, M.J.; Alam, O.; Alam, J.; Bano, F.; Alam, P.; Shrivastava, N. Recent Review on Indole: A privileged scaffold structure. Int. J. Pharma Sci. Res. 2016, 7, 51–62. [Google Scholar]
- Chen, S.; Liu, J.; Gong, H.; Yang, D. Identification and Antibacterial Activity of Secondary Metabolites from Taxus Endophytic Fungus. Chin. J. Biotechnol. 2009, 25, 368–374. [Google Scholar] [PubMed]
- Kumari, N.; Menghani, E.; Mithal, R. GCMS Analysis of Compounds Extracted from Actinomycetes AIA6 Isolates and Study of Its Antimicrobial Efficacy. Indian J. Chem. Technol. 2019, 26, 362–370. [Google Scholar]
- Ramya, B.; Malarvili, T.; Velavan, S. GC-MS Analysis of Bioactive Compounds in Bryonopsis Laciniosa Fruit Extract. Int. J. Pharm. Sci. Res. 2015, 6, 3375–3379. [Google Scholar]
- Mooney, E.C.; Holden, S.E.; Xia, X.J.; Li, Y.; Jiang, M.; Banson, C.N.; Zhu, B.; Sahingur, S.E. Quercetin Preserves Oral Cavity Health by Mitigating Inflammation and Microbial Dysbiosis. Front. Immunol. 2021, 12, 774273. [Google Scholar] [CrossRef] [PubMed]
- Babar, A.G. Antifungal Activity and Investigation of Bioactive Compounds of Marine Intertidal Bivalve Gafrarium Divaricatum from West Coast of India. Int. J. Pure Appl. Biosci. 2016, 4, 211–217. [Google Scholar] [CrossRef]
- Nakkeeran, S.; Priyanka, R.; Rajamanickam, S.; Sivakumar, U. Bacillus amyloliquefaciens Alters the Diversity of Volatile and Non-Volatile Metabolites and Induces the Expression of Defence Genes for the Management of Botrytis Leaf Blight of Lilium under Protected Conditions. J. Plant Pathol. 2020, 102, 1179–1189. [Google Scholar] [CrossRef]
- Younis, A.A.; Saleh, H.A. Phytochemical Screening and Assessment of Antioxidant and Antimicrobial Potentialities of Two Egyptian Medicinal Plants. Egypt. J. Pure Appl. Sci. 2021, 59, 49–57. [Google Scholar] [CrossRef]
- Ahmad Mustafa, F.N. Green Synthesis of Isopropyl Palmitate Using Immobilized Candida Antarctica Lipase: Process Optimization Using Response Surface Methodology. Clean. Eng. Technol. 2022, 8, 100516. [Google Scholar] [CrossRef]
- Kumari, N.; Menghani, E.; Mithal, R. Bioactive Compounds Characterization and Antibacterial Potentials of Actinomycetes Isolated from Rhizospheric Soil. J. Sci. Ind. Res. 2019, 78, 793–798. [Google Scholar]
- Parthasarathy, R. Ethnic Quotas as Term-Limits: Caste and Distributive Politics in South India. Comp. Political Stud. 2017, 50, 1735–1767. [Google Scholar] [CrossRef]
- Arya, A.; Kumar, S.; Kain, D.; Ahanger, A.M.; Suryavanshi, A.; Vandana. Unfolding the Chemical Composition, Antioxidant and Antibacterial Activities of Drymaria cordata (Linn.) Willd. against Chloramphenicol-Resistant Bacillus subtilis and β-Lactams-Resistant Pseudomonas aeruginosa. Vegetos 2023, 1–10. [Google Scholar] [CrossRef]
- Babatunde, D.E.; Otusemade, G.O.; Efeovbokhan, V.E.; Ojewumi, M.E.; Bolade, O.P.; Owoeye, T.F. Chemical Composition of Steam and Solvent Crude Oil Extracts from Azadirachta indica Leaves. Chem. Data Collect. 2019, 20, 100208. [Google Scholar] [CrossRef]
- Kalaba, M.H.; Sultan, M.H.; Elbahnasawy, M.A.; El-Didamony, S.E.; Bakary, N.M.E.; Sharaf, M.H. First Report on Isolation of Mucor Bainieri from Honeybees, Apis mellifera: Characterization and Biological Activities. Biotechnol. Rep. 2022, 36, e00770. [Google Scholar] [CrossRef] [PubMed]
- Selvamani, K.; Tadigiri, S.; Das, D. Isolation and Characterization of Chemical Constituents from B. amyloliquefaciens and Their Nematicidal Activity. J. Entomol. Zool. Stud. 2020, 8, 2062–2066. [Google Scholar]
- Zhu, F.; Zhu, C.; Doyle, E.; Gao, J. Fate of Di (2-Ethylhexyl) Phthalate in Different Soils and Associated Bacterial Community Changes. Sci. Total Environ. 2018, 637, 460–469. [Google Scholar] [CrossRef]
- Saboon; Bibi, Y.; Ayoubi, S.A.; Afzal, T.; Gilani, S.; Malik, K.; Qayyum, A.; Hussain, M.; Kumar, S. Antioxidant-Activity-Guided Purification and Separation of Octocrylene from Saussurea heteromalla. Separations 2023, 10, 107. [Google Scholar] [CrossRef]
- Stevenson, J.; Luu, W.; Kristiana, I.; Brown, A.J. Squalene Mono-Oxygenase, a Key Enzyme in Cholesterol Synthesis, Is Stabilized by Unsaturated Fatty Acids. Biochem. J. 2014, 461, 435–442. [Google Scholar] [CrossRef] [PubMed]
- Eramma, N.; Patil, S.J. Exploration of the Biomolecules in roots of Flacourtia indica (Burm. F) Merr. Methanol Extract by Chromatography Approach. Lett. Appl. NanoBioSci. 2023, 12, 166–177. [Google Scholar]
- Tyagi, S.; Singh, R.K.; Tiwari, S.P. Anti-Enterococcal and Anti-Oxidative Potential of a Thermophilic Cyanobacterium, Leptolyngbya sp. HNBGU 003. Saudi J. Biol. Sci. 2021, 28, 4022–4028. [Google Scholar] [CrossRef]
- Saleh, A.E.; Ul-Hassan, Z.; Zeidan, R.; Al-Shamary, N.; Al-Yafei, T.; Alnaimi, H.; Higazy, N.S.; Migheli, Q.; Jaoua, S. Biocontrol Activity of Bacillus megaterium BM344-1 against Toxigenic Fungi. ACS Omega 2021, 6, 10984–10990. [Google Scholar] [CrossRef]
- Guo, C.; Chen, Y.; Wu, D.; Du, Y.; Wang, M.; Liu, C.; Chu, J.; Yao, X. Transcriptome Analysis Reveals an Essential Role of Exogenous Brassinolide on the Alkaloid Biosynthesis Pathway in Pinellia Ternata. Int. J. Mol. Sci. 2022, 23, 10898. [Google Scholar] [CrossRef] [PubMed]
- Chakraborty, B.; Suresh, R.; Almansour, A.I.; Gunasekaran, P.; Nayaka, S. Saudi Journal of Biological Sciences Bioprospection and Secondary Metabolites Profiling of Marine Streptomyces levis Strain KS46. Saudi J. Biol. Sci. 2022, 29, 667–679. [Google Scholar] [CrossRef]
- Uyan, A.; Turan, C.; Erdogan-Eliuz, E.A.; Sangun, M.K. Antimicrobial Properties of Bioactive Compounds Isolated from Epidermal Mucus in Two Ray Species (Dasyatis marmorata and Gymnura altavela). Trop. J. Pharm. Res. 2020, 19, 2115–2121. [Google Scholar] [CrossRef]
- Siddharthan, N.; Balagurunathan, R.; Venkatesan, S.; Hemalatha, N. Bio-Efficacy of Geobacillus thermodenitrificans PS41 against Larvicidal, Fungicidal, and Plant Growth–Promoting Activities. Environ. Sci. Pollut. Res. 2022, 30, 42596–42607. [Google Scholar] [CrossRef]
- Kanbak, S.A.; Koksal, M.; Sahin, F.; Erol, D.D. Synthesis of New 4(1H)-Pyridinone Derivatives and Their Antibacterial Activity. Rev. Chim. 2009, 60, 888–892. [Google Scholar]
- Łukowska-Chojnacka, E.; Kowalkowska, A.; Gizińska, M.; Koronkiewicz, M.; Staniszewska, M. Synthesis of Tetrazole Derivatives Bearing Pyrrolidine Scaffold and Evaluation of Their Antifungal Activity against Candida albicans. Eur. J. Med. Chem. 2019, 164, 106–120. [Google Scholar] [CrossRef]
- Dutta, J.; Thakur, D. Evaluation of Antagonistic and Plant Growth Promoting Potential of Streptomyces sp. TT3 Isolated from Tea (Camellia Sinensis) Rhizosphere Soil. Curr. Microbiol. 2020, 77, 1829–1838. [Google Scholar] [CrossRef]
- Sakthiselvan, P.; Madhumathi, R.; Meenambiga, S.S. Moronic Acid: An Antiviral for Herpes Simplex Virus. In A Centum of Valuable Plant Bioactives; Academic Press: Berlin/Heidelberg, Germany, 2021; pp. 143–158. [Google Scholar] [CrossRef]
- Díaz-Pérez, A.L.; Díaz-Pérez, C.; Campos-García, J. Bacterial L-Leucine Catabolism as a Source of Secondary Metabolites. Rev. Environ. Sci. Bio/Technol. 2016, 15, 1–29. [Google Scholar] [CrossRef]
- Jung, H.; Hilger, D.; Raba1, M. The Na+/L-Proline Transporter PutP. Front. Biosci. 2012, 17, 745–759. [Google Scholar] [CrossRef] [PubMed]
- Shwaish, T.; Al-Imarah, F.J.M.; Jasim, F.A. Wound Healing Capacity, Antibacterial Activity, and GC-MS Analysis of Bienertia sinuspersici Leaves Extract. J. Phys. Conf. Ser. 2019, 1294, 062056. [Google Scholar] [CrossRef]
- Rhetso, T.; Shubharani, R.; Roopa, M.S.; Sivaram, V. Chemical Constituents, Antioxidant, and Antimicrobial Activity of Allium chinense G. Don. Future J. Pharm. Sci. 2020, 6, 102. [Google Scholar] [CrossRef]
- Touria Ould Bellahcen, M.C. Chemical Composition and Antibacterial Activity of the Essential Oil of Spirulina platensis from Morocco. J. Essent. Oil Bear. Plants 2019, 22, 1265–1276. [Google Scholar] [CrossRef]
- Singh, P.; Singh, J.; Ray, S.; Vaishnav, A.; Jha, P.; Singh, R.K.; Singh, H. Microbial Volatiles (MVOCs) Induce Tomato Plant Growth and Disease Resistance Against Wilt Pathogen Fusarium oxysporum f.sp. lycopersici. J. Plant Growth Regul. 2023, 1–14. [Google Scholar] [CrossRef]
- Ladkau, N.; Assmann, M.; Schrewe, M.; Julsing, M.K.; Schmid, A.; Bühler, B. Efficient Production of the Nylon 12 Monomer ω-Aminododecanoic Acid Methyl Ester from Renewable Dodecanoic Acid Methyl Ester with Engineered Escherichia coli. Metab. Eng. 2016, 36, 1–9. [Google Scholar] [CrossRef]
- Ashraf, M.F.M.R.; Foolad, M.R. Roles of Glycine Betaine and Proline in Improving Plant Abiotic Stress Resistance. Environ. Exp. Bot. 2007, 59(2), 206–216. [Google Scholar] [CrossRef]
- He, K.; Zhang, T.; Zhang, S.; Sun, Z.; Zhang, Y.; Yuan, Y.; Jia, X. Tunable Functionalization of Saturated C–C and C–H Bonds of N,N′-Diarylpiperazines Enabled by tert-Butyl Nitrite (TBN) and NaNO2 Systems. Org. Lett. 2019, 21, 5030–5034. [Google Scholar] [CrossRef]
- Vorobjeva, L.I.; Khodjaev, E.Y.; Vorobjeva, N.V. Propionic Acid Bacteria as Probiotics. Microb. Ecol. Health Dis. 2008, 20, 109–112. [Google Scholar] [CrossRef]
- Rathod, S.V.; Shinde, K.W.; Kharkar, P.S.; Shah, C.P.; Aruna, K.; Raut, D.A. Synthesis, Molecular Docking and Biological Evaluation of New Quinoline Analogues as Potent Anti-Breast Cancer and Antibacterial Agents. Indian J. Chem. Sect. B Org. Med. Chem. 2021, 60B, 1215–1222. [Google Scholar] [CrossRef]
- Monjil, M.S.; Takemoto, D.; Kawakita, K. Defense Induced by a Bis-Aryl Methanone Compound Leads to Resistance in Potato against Phytophthora infestans. J. Gen. Plant Pathol. 2014, 80, 38–49. [Google Scholar] [CrossRef]
- Singh, J.; Sharma, S.; Kaur, A.; Vikal, Y.; Cheema, A.K.; Bains, B.K.; Kaur, N.; Gill, G.K.; Malhotra, P.K.; Kumar, A.; et al. Marker-Assisted Pyramiding of Lycopene-ε-Cyclase, β-Carotene Hydroxylase1 and Opaque2 Genes for Development of Biofortified Maize Hybrids. Sci. Rep. 2021, 11, 12642. [Google Scholar] [CrossRef] [PubMed]
- Daood, U.; Matinlinna, J.P.; Pichika, M.R.; Mak, K.K.; Nagendrababu, V.; Fawzy, A.S. A Quaternary Ammonium Silane Antimicrobial Triggers Bacterial Membrane and Biofilm Destruction. Sci. Rep. 2020, 10, 10970. [Google Scholar] [CrossRef] [PubMed]
- Das, P.; Devi, N.; Gaur, N.; Goswami, S.; Dutta, D.; Dubey, R.; Puzari, A. Acrylonitrile Adducts: Design, Synthesis and Biological Evaluation as Antimicrobial, Haemolytic and Thrombolytic Agent. Sci. Rep. 2023, 13, 6209. [Google Scholar] [CrossRef] [PubMed]
- Yadav, B.; Jogawat, A.; Rahman, M.S.; Narayan, O.P. Secondary Metabolites in the Drought Stress Tolerance of Crop Plants: A Review. Gene Rep. 2021, 23, 101040. [Google Scholar] [CrossRef]
- Harikrishnan, S.; Parivallal, M.; Alsalhi, M.S.; Sudarshan, S.; Jayaraman, N.; Devanesan, S.; Rajasekar, A.; Jayalakshmi, S. Characterization of Active Lead Molecules from Lissocarinus orbicularis with Potential Antimicrobial Resistance Inhibition Properties. J. Infect. Public Health 2021, 14, 1903–1910. [Google Scholar] [CrossRef] [PubMed]
- Kumaresan, S.; Senthilkumar, V.; Stephen, A.; Balakumar, B.S. GC-MS analysis and pass-assisted prediction of biological activity spectra of extract of Phomopsis sp. isolated from Andrographis paniculata. World J. Pharm. Res. 2015, 4, 1035–1053. [Google Scholar]
- Trivedi, D.K.; Sinclair, E.; Xu, Y.; Sarkar, D.; Walton-Doyle, C.; Liscio, C.; Banks, P.; Milne, J.; Silverdale, M.; Kunath, T.; et al. Discovery of Volatile Biomarkers of Parkinson’s Disease from Sebum. ACS Cent. Sci. 2019, 5, 599–606. [Google Scholar] [CrossRef]
- Varsha, K.K.; Devendra, L.; Shilpa, G.; Priya, S.; Pandey, A.; Nampoothiri, K.M. 2,4-Di-tert-butyl Phenol as the Antifungal, Antioxidant Bioactive Purified from a Newly Isolated Lactococcus sp. Int. J. Food Microbiol. 2015, 211, 44–50. [Google Scholar] [CrossRef]
- Abdullah, R. Insecticidal Activity of Secondary Metabolites of Locally Isolated Fungal Strains against Some Cotton Insect Pests. J. Plant Prot. Pathol. 2019, 10, 647–653. [Google Scholar] [CrossRef]
- Rani, A.; Saini, K.C.; Bast, F.; Mehariya, S.; Bhatia, S.K.; Lavecchia, R.; Zuorro, A. Microorganisms: A Potential Source of Bioactive Molecules for Antioxidant Applications. Molecules 2021, 26, 1142. [Google Scholar] [CrossRef]
- Sharma, S.; Chandra, D.; Sharma, A.K. Rhizosphere Plant–Microbe Interactions Under Abiotic Stress. In Rhizosphere Biology: Interactions between Microbes and Plants; Springer: Singapore, 2021; pp. 195–216. [Google Scholar] [CrossRef]
- Javed, S.; Javaid, A.; Al-Taie, A.H.; Zahid, M. Identification of Antimicrobial Compounds from n-Hexane Stem Extract of Kochia indica by GC-MS Analysis. Mycopath 2018, 16, 51–55. [Google Scholar]
- Ahmad, R.; Ahmad, T.; Hussain, B. Proceedings of International Conference on Recent Advances in Space Technologies (IEEE Cat. No.03EX743); IEEE: New York, NY, USA, 2011; ISBN 9788195663415. [Google Scholar]
- Rachmawaty; Mu’Nisa, A.; Hasri; Pagarra, H.; Hartati; Qureshi, M.Z. Active Compounds Extraction of Cocoa Pod Husk (Thebroma cacao L.) and Potential as Fungicides. J. Phys. Conf. Ser. 2018, 1028, 012013. [Google Scholar] [CrossRef]
- Duraisamy, M.; Raja, S. Analysis of Bioactive Compounds by Gas Chromatography-Mass Spectrum and Anti-Bacterial Activity of Zonaria crenata. Aegaeum J. 2020, 8, 829–844. [Google Scholar] [CrossRef]
- Younus, I.; Khan, S.J.; Maqbool, S.; Begum, Z. Anti-Fungal Therapy via Incorporation of Nanostructures: A Systematic Review for New Dimensions. Phys. Scr. 2022, 97, 012001. [Google Scholar] [CrossRef]
- Ser, H.L.; Palanisamy, U.D.; Yin, W.F.; Abd Malek, S.N.; Chan, K.G.; Goh, B.H.; Lee, L.H. Presence of Antioxidative Agent, Pyrrolo[1,2-a]pyrazine-1,4-dione, Hexahydro- in Newly Isolated Streptomyces mangrovisoli sp. nov. Front. Microbiol. 2015, 6, 854. [Google Scholar] [CrossRef] [PubMed]
- Komansilan, A.; Abadi, A.L.; Yanuwiadi, B.; Kaligis, D.A. Isolation and Identification of Biolarvicide from Soursop (Annona muricata Linn) Seeds to Mosquito (Aedes aegypti) Larvae. Int. J. Eng. Technol. 2012, 12, 28–32. [Google Scholar]
- Momodu, I.B.; Okungbowa, E.S.; Agoreyo, B.O.; Maliki, M.M. Gas Chromatography—Mass Spectrometry Identification of Bioactive Compounds in Methanol and Aqueous Seed Extracts of Azanza garckeana Fruits. Niger. J. Biotechnol. 2022, 38, 25–38. [Google Scholar] [CrossRef]
- Ansari, M.W.; Gill, S.S.; Tuteja, N. Piriformospora indica a Powerful Tool for Crop Improvement. Proc. Indian Natl. Sci. Acad. 2014, 80, 317–324. [Google Scholar] [CrossRef]
- Sahu, P.K.; Jayalakshmi, K.; Tilgam, J.; Gupta, A.; Nagaraju, Y.; Kumar, A.; Rajput, V.D.; Vikram, M.; Rajawat, S. ROS Generated from Biotic Stress: Effects on Plants and Alleviation by Endophytic Microbes. Front. Plant Sci. 2022, 13, 1042936. [Google Scholar] [CrossRef] [PubMed]
- Rani, S.V.G.; Murugaiah, K. GC-MS Determination of Bioactive Compounds in Azima tetracantha Leaves. World J. Pharm. Res. 2015, 4, 2225–2231. [Google Scholar]
- Suharti, W.S.; Tini, E.W.; Istiqomah, D. Antimicrobial Activity of Kaempferia galanga against Plant Pathogen on Rice. Biodiversitas 2023, 24, 1320–1326. [Google Scholar]
- Saravanan, R.; Pemiah, B.; Narayanan, M.; Ramalingam, S. In Vitro Cytotoxic and Gas Chromatography-Mass Spectrometry Studies on Orthosiphon stamineus Benth. (Leaf) against MCF–7 Cell Lines. Asian J. Pharm. Clin. Res. 2017, 10, 129–135. [Google Scholar] [CrossRef][Green Version]
- Okoro, E.E.; Osoniyi, O.R.; Jabeen, A.; Shams, S.; Choudhary, M.I.; Onajobi, F.D. Anti-Proliferative and Immunomodulatory Activities of Fractions from Methanol Root Extract of Abrus precatorius L. Clin. Phytosci. 2019, 5, 45. [Google Scholar] [CrossRef]
- Adnan, M.; Nazim Uddin Chy, M.; Mostafa Kamal, A.T.M.; Azad, M.O.K.; Paul, A.; Uddin, S.B.; Barlow, J.W.; Faruque, M.O.; Park, C.H.; Cho, D.H. Investigation of the Biological Activities and Characterization of Bioactive Constituents of Ophiorrhiza rugosa var. prostrata (D.Don) & Mondal Leaves through in Vivo, in Vitro, and in Silico Approaches. Molecules 2019, 24, 1367. [Google Scholar] [CrossRef]
- Ponnamma, S.U.; Manjunath, K. GC-MS Analysis of Phytocomponents in the Methanolic Extract of Justicia wynaadensis (NEES) T. Anders. Int. J. Pharma Bio Sci. 2012, 3, 570–576. [Google Scholar]
- Chrząszcz, M.; Miazga-Karska, M.; Klimek, K.; Dybowski, M.P.; Typek, R.; Tchórzewska, D.; Dos Santos Szewczyk, K. The Anti-Acne Potential and Chemical Composition of Knautia drymeia Heuff. and Knautia macedonica Griseb Extracts. Int. J. Mol. Sci. 2023, 24, 9188. [Google Scholar] [CrossRef]
- Kandasamy, S.; Sahu, S.K.; Kandasamy, K. In Silico Studies on Fungal Metabolite against Skin Cancer Protein (4,5-Diarylisoxazole HSP90 Chaperone). Int. Sch. Res. Not. 2012, 2012, 626214. [Google Scholar] [CrossRef]
- Oviya, R.; Thiruvudainambi, S.; Ramamoorthy, V.; Vendan, R.T.; Vellaikumar, S. Gas Chromatography Mass Spectrometry (GCMS) Analysis of the Antagonistic Potential of Trichoderma hamatum against Fusarium oxysporum f. sp. cepae Causing Basal Rot Disease of Onion. J. Biol. Control 2022, 36, 17–30. [Google Scholar] [CrossRef]
- Sen, S.; Dehingia, M.; Talukdar, N.C.; Khan, M. Chemometric Analysis Reveals Links in the Formation of Fragrant Bio-Molecules during Agarwood (Aquilaria malaccensis) and Fungal Interactions. Sci. Rep. 2017, 7, 44406. [Google Scholar] [CrossRef] [PubMed]
- Ain, Q.U.; Asad, S.; Jamal, A.; Arif, M.; Mahmood-Ul-hassan, M. Phytochemical Analysis and Antifungal Activity of Gymnosperm against Fusarium Wilt of Banana. Appl. Ecol. Environ. Res. 2021, 19, 2477–2493. [Google Scholar] [CrossRef]
- O’Leary, J.; Hiscox, J.; Eastwood, D.C.; Savoury, M.; Langley, A.; McDowell, S.W.; Rogers, H.J.; Boddy, L.; Müller, C.T. The Whiff of Decay: Linking Volatile Production and Extracellular Enzymes to Outcomes of Fungal Interactions at Different Temperatures. Fungal Ecol. 2019, 39, 336–348. [Google Scholar] [CrossRef]
- Abu Zeid, I.M.; Al-Thobaiti, S.A.; EL Hag, G.A.; Alghamdi, S.A.; Umar, A.; Abdalla Ahmed Hamdi, O. Phytochemical and GC-MS Analysis of Bioactive Compounds from Balanites aegyptiaca. Acta Sci. Pharm. Sci. 2019, 3, 129–134. [Google Scholar] [CrossRef]
- Jiménez-Teja, D.; Daoubi, M.; Collado, I.G.; Hernández-Galán, R. Lipase-Catalyzed Resolution of 5-Acetoxy-1,2-dihydroxy-1,2,3,4-tetrahydronaphthalene. Application to the Synthesis of (+)-(3R,4S)-cis-4-Hydroxy-6-deoxyscytalone, a Metabolite Isolated from Colletotrichum acutatum. Tetrahedron 2009, 65, 3392–3396. [Google Scholar] [CrossRef]
- Zhang, Y.; Berman, A.; Shani, E. Plant Hormone Transport and Localization: Signaling Molecules on the Move. Annu. Rev. Plant Biol. 2023, 74, 453–479. [Google Scholar] [CrossRef]
- Yang, H.; Luo, P. Changes in Photosynthesis Could Provide Important Insight into the Interaction between Wheat and Fungal Pathogens. Int. J. Mol. Sci. 2021, 22, 8865. [Google Scholar] [CrossRef]
- Sebastian, J.; Hegde, K.; Kumar, P.; Rouissi, T.; Brar, S.K. Bioproduction of Fumaric Acid: An Insight into Microbial Strain Improvement Strategies. Crit. Rev. Biotechnol. 2019, 39, 817–834. [Google Scholar] [CrossRef]
- Vijay, K.; Hassan, S.; Govarthanan, M.; Kavitha, T. Biosurfactant Lipopeptides and Polyketide Biosynthetic Gene in Rhizobacterium Achromobacter kerstersii to Induce Systemic Resistance in Tomatoes. Rhizosphere 2022, 23, 100558. [Google Scholar] [CrossRef]
- Palani, V.; Shanmugasundaram, M.; Maluventhen, V.; Chinnaraj, S.; Liu, W.; Balasubramanian, B.; Arumugam, M. Phytoconstituents and Their Potential Antimicrobial, Antioxidant and Mosquito Larvicidal Activities of Goniothalamus wightii Hook. F. & Thomson. Arab. J. Sci. Eng. 2020, 45, 4541–4555. [Google Scholar] [CrossRef]
- Ratheesh, M.; Sunil, S.; Sheethal, S.; Jose, S.P.; Sandya, S.; Ghosh, O.S.N.; Rajan, S.; Jagmag, T.; Tilwani, J. Anti-Inflammatory and Anti-COVID-19 Effect of a Novel Polyherbal Formulation (Imusil) via Modulating Oxidative Stress, Inflammatory Mediators and Cytokine Storm. Inflammopharmacology 2022, 30, 173–184. [Google Scholar] [CrossRef]
- Aziz, S.D.A.; Jafarah, N.F.; Yusof, Z.N.B. Phytol-Containing Seaweed Extracts as Control for Ganoderma boninense. J. Oil Palm Res. 2019, 31, 238–247. [Google Scholar] [CrossRef]
- Park, H.B.; Lee, B.; Kloepper, J.W.; Ryu, C.M. One Shot-Two Pathogens Blocked: Exposure of Arabidopsis to Hexadecane, a Long Chain Volatile Organic Compound, Confers Induced Resistance against Both Pectobacterium carotovorum and Pseudomonas syringae. Plant Signal. Behav. 2013, 8, e24619. [Google Scholar] [CrossRef]
- Parmagnani, A.S.; Kanchiswamy, C.N.; Paponov, I.A.; Bossi, S.; Malnoy, M.; Maffei, M.E. Bacterial Volatiles (MVOC) Emitted by the Phytopathogen Erwinia amylovora Promote Arabidopsis thaliana Growth and Oxidative Stress. Antioxidants 2023, 12, 600. [Google Scholar] [CrossRef]
- Majrashi, T.A.; Sabt, A.; Abd El Salam, H.A.; Al-Ansary, G.H.; Hamissa, M.F.; Eldehna, W.M. An Updated Review of Fatty Acid Residue-Tethered Heterocyclic Compounds: Synthetic Strategies and Biological Significance. RSC Adv. 2023, 13, 13655–13682. [Google Scholar] [CrossRef]
- Zheng, L.; Yan, X.; Xu, J.; Chen, H.; Lin, W. Hymeniacidon Perleve Associated Bioactive Bacterium Pseudomonas sp. NJ6-3-1. Appl. Biochem. Microbiol. 2005, 41, 29–33. [Google Scholar] [CrossRef]
- Taghavi, N. Enhancement in Biodegradation of Thermoplastics Using UV-Pretreatment and Biosurfactant. Ph.D. Thesis, The University of Auckland, Auckland, New Zealand, 2021. [Google Scholar]
- Sehim, A.E.; Amin, B.H.; Yosri, M.; Salama, H.M.; Alkhalifah, D.H.; Alwaili, M.A.; Elghaffar, R.Y.A. GC-MS Analysis, Antibacterial, and Anticancer Activities of Hibiscus sabdariffa L. Methanolic Extract: In Vitro and In Silico Studies. Microorganisms 2023, 11, 1601. [Google Scholar] [CrossRef]
- Zhang, X.; Li, Q.; Xu, W.; Zhao, H.; Guo, F.; Wang, P.; Wang, Y.; Ni, D.; Wang, M.; Wei, C. Identification of MTP Gene Family in Tea Plant (Camellia sinensis L.) and Characterization of CsMTP8.2 in Manganese Toxicity. Ecotoxicol. Environ. Saf. 2020, 202, 110904. [Google Scholar] [CrossRef]
- Adesanwo, J.K.; Ajayi, I.S.; Ajayi, O.S.; Igbeneghu, O.A.; McDonald, A.G. Identification of Chemical Constituents and Evaluation of the Antibacterial Activity of Methanol Extract and Fractions of the Leaf of Melanthera scandens (Schum. et Thonn.) Roberty. J. Explor. Res. Pharmacol. 2019, 4, 31–40. [Google Scholar] [CrossRef]
- Hawar, S.N.; Taha, Z.K.; Hamied, A.S.; Al-Shmgani, H.S.; Sulaiman, G.M.; Elsilk, S.E. Antifungal Activity of Bioactive Compounds Produced by the Endophytic Fungus Paecilomyces sp. (JN227071.1) against Rhizoctonia solani. Int. J. Biomater. 2023, 2023, 2411555. [Google Scholar] [CrossRef]
- Idris, N. Potential of Hexadecanoic Acid as Antimicrobials in Bacteria and Fungi That Cause Decay in Mustard Greens Brassica juncea L. Int. J. Appl. Biol. 2022, 6, 36–42. [Google Scholar]
- Phukan, H.; Brahma, R.; Mitra, P.K. An Endophytic Fungus Associated with Kayea assamica (King & Prain): A Study on Its Molecular Phylogenetics and Natural Products. S. Afr. J. Bot. 2020, 134, 314–321. [Google Scholar] [CrossRef]
- Jiao, S.; Chen, W.; Wang, E.; Wang, J.; Liu, Z.; Li, Y.; Wei, G. Microbial Succession in Response to Pollutants in Batch-Enrichment Culture. Sci. Rep. 2016, 6, 21791. [Google Scholar] [CrossRef]
- Boadu, A.; Karpoormath, R.; Nlooto, M. Spondias Mombin: Biosafety and GC–MS Analysis of Anti-Viral Compounds from Crude Leaf Extracts. Adv. Tradit. Med. 2023, 1–24. [Google Scholar] [CrossRef]
- Firdaus, M.; Kartikaningsih, H.; Sulifah, U. Sargassum spp Extract Inhibits the Growth of Foodborne Illness Bacteria. AIP Conf. Proc. 2019, 2202, 020083. [Google Scholar] [CrossRef]
- Williams, A.; Langridge, H.; Straathof, A.L.; Muhamadali, H.; Hollywood, K.A.; Goodacre, R.; de Vries, F.T. Root Functional Traits Explain Root Exudation Rate and Composition across a Range of Grassland Species. J. Ecol. 2022, 110, 21–33. [Google Scholar] [CrossRef]
- Shahbaz, E.; Ali, M.; Shafiq, M.; Atiq, M.; Hussain, M.; Balal, R.M.; Sarkhosh, A.; Alferez, F.; Sadiq, S.; Shahid, M.A. Citrus Canker Pathogen, Its Mechanism of Infection, Eradication, and Impacts. Plants 2023, 12, 123. [Google Scholar] [CrossRef]
- Chuah, X.; Okechukwu, P.; Amini, F.; Teo, S. Eicosane, Pentadecane and Palmitic Acid: The Effects in In Vitro Wound Healing Studies. Asian Pac. J. Trop. Biomed. 2018, 8, 490–499. [Google Scholar] [CrossRef]
- Ghorbani, A.; Tafteh, M.; Roudbari, N.; Pishkar, L.; Zhang, W.; Wu, C. Piriformospora indica Augments Arsenic Tolerance in Rice (Oryza sativa) by Immobilizing Arsenic in Roots and Improving Iron Translocation to Shoots. Ecotoxicol. Environ. Saf. 2021, 209, 111793. [Google Scholar] [CrossRef]
- Laport, M.; Santos, O.; Muricy, G. Marine Sponges: Potential Sources of New Antimicrobial Drugs. Curr. Pharm. Biotechnol. 2009, 10, 86–105. [Google Scholar] [CrossRef]
- Dimmock, J.; Turner, W.; Baker, H. Antimicrobial Evaluation of Diastereoisomeric 2-Dimethylaminomethyl-6-phenylcyclohexanols and Related Esters. J. Pharm. Sci. Res. 1975, 64, 995–997. [Google Scholar] [CrossRef]
- Hostettmann–Kaldas, M.; Nakanishi, K. Moronic Acid, a Simple Triterpenoid Keto Acid with Antimicrobial Activity Isolated from Ozoroa mucronata. Planta Medica 1979, 37, 358–360. [Google Scholar] [CrossRef]
- Huang, Y.; Sun, C.; Guan, X.; Lian, S.; Li, B.; Wang, C. Butylated Hydroxytoluene Induced Resistance Against Botryosphaeria dothidea in Apple Fruit. Front. Microbiol. 2021, 11, 599062. [Google Scholar] [CrossRef]
- Qian, F.; Huang, X.; Su, X.; Bao, Y. Responses of Microbial Communities and Metabolic Profiles to the Rhizosphere of Tamarix ramosissima in Soils Contaminated by Multiple Heavy Metals. J. Hazard. Mater. 2022, 438, 129469. [Google Scholar] [CrossRef]
- Fathi, M.; Ghane, M.; Pishkar, L. Phytochemical Composition, Antibacterial, and Antibiofilm Activity of Malva sylvestris Against Human Pathogenic Bacteria. Jundishapur J. Nat. Pharm. Prod. 2022, 17, e114164. [Google Scholar] [CrossRef]
- Nautiyal, V.; Pradhan, S.; Dubey, R.C. In Silico Molecular Docking Analysis and ADME Prediction of Cow Urine Derived 1-Heneicosanol against Some Bacterial Proteins. Vegetos 2023, 38, 1–7. [Google Scholar] [CrossRef]
- Salim, S.A. Identification of Active Pharmaceutical Ingredients in Thevetia neriifolia Juss Leaf Callus Using Analysis of GC-MS. Indian J. Public Health Res. Dev. 2018, 9, 1019–1023. [Google Scholar]
- Li, J.; Wang, Y.; Zheng, L.; Li, Y.; Zhou, X.; Li, J.; Gu, D.; Xu, E.; Lu, Y.; Chen, X.; et al. The Intracellular Transporter AtNRAMP6 Is Involved in Fe Homeostasis in Arabidopsis. Front. Plant Sci. 2019, 10, 1124. [Google Scholar] [CrossRef]
- Angeli, A.; Petrou, A.; Kartsev, V.; Lichitsky, B.; Komogortsev, A.; Capasso, C.; Geronikaki, A.; Supuran, C.T. Synthesis, Biological and In Silico Studies of Griseofulvin and Usnic Acid Sulfonamide Derivatives as Fungal, Bacterial and Human Carbonic Anhydrase Inhibitors. Int. J. Mol. Sci. 2023, 24, 2802. [Google Scholar] [CrossRef]
- Xuan, T.D.; Roni, Y.; Andriana, Y.; Khanh, T.D.; Anh, T.T.T.; Kakar, K.; Haqani, M.I. Chemical Profile, Antioxidant Activities and Allelopathic Potential of Liquid Waste from Germinated Brown Rice. Allelopath. J. 2018, 45, 89–100. [Google Scholar] [CrossRef]
- Ahmad, K.S. Environmental Contaminant 2-Chloro-N-(2,6-diethylphenyl)-N-(methoxymethyl)acetamide Remediation via Xanthomonas axonopodis and Aspergillus niger. Environ. Res. 2020, 182, 109117. [Google Scholar] [CrossRef]
- Vázquez-Fuentes, S.; Pelagio-Flores, R.; López-Bucio, J.; Torres-Gavilán, A.; Campos-García, J.; de la Cruz, H.R.; López-Bucio, J.S. N-Vanillyl-Octanamide Represses Growth of Fungal Phytopathogens In Vitro and Confers Postharvest Protection in Tomato and Avocado Fruits against Fungal-Induced Decay. Protoplasma 2021, 258, 729–741. [Google Scholar] [CrossRef]
- Minerdi, D.; Maggini, V.; Fani, R. Volatile Organic Compounds: From Figurants to Leading Actors in Fungal Symbiosis. FEMS Microbiol. Ecol. 2021, 97, fiab067. [Google Scholar] [CrossRef]
- Kawle, P.R. Synthesis and Antituberculosis Action of Symmetric Acridin-9-yl-bisbenzothiazol-2-yl-amines. Indian J. Chem. IJC 2023, 62, 691–695. [Google Scholar] [CrossRef]
- Brodzka, A.; Kowalczyk, P.; Trzepizur, D.; Koszelewski, D.; Kramkowski, K.; Szymczak, M.; Wypych, A.; Lizut, R.; Ostaszewski, R. The Synthesis and Evaluation of Diethyl Benzylphosphonates as Potential Antimicrobial Agents. Molecules 2022, 27, 6865. [Google Scholar] [CrossRef]

| S. No. | Metabolites (S. indica/S. indica; As) | Metabolites (S. indica + Z. sp. ISTPL4/S. indica + Z. sp. ISTPL4; As) |
|---|---|---|
| 1 | 2,4-Di-tert-butyl-phenol) phosphate | 2,4-Di-tert-butyl-phenol) phosphate |
| 2 | Cyclo(L-prolyl-L-valine) | Cyclo(L-prolyl-L-valine) |
| 3 | 1,2-Benzenedicarboxylic acid, bis (2-methyl propyl) ester | 1,2-Benzenedicarboxylic acid, bis (2-methyl propyl) ester |
| 4 | 7,9-Di-tert-butyl-1-oxaspiro (4,5) deca-a-6,9-diene-2,8-dione | 7,9-Di-tert-butyl-1-oxaspiro (4,5) deca-a-6,9-diene-2,8-dione |
| 5 | Hexadecenoic acid, methyl ester | Hexadecenoic acid, methyl ester |
| 6 | Pyrrole[1,2-a]pyrazine-1,4-dione, hexahyd dro-3-(2-methyl propyl) | octadecanoic acid, 3-oxo-, ethyl ester |
| 7 | 1,2-Benzenedicarboxylic acid, butyl octyl ester | Olean-18-ene |
| 8 | Methyl stearate | L-Proline |
| 9 | 2-Ethylbutyric acid, eicosyl ester | Glycerol 1-palmitate |
| 10 | 2-(4-Hydroxy-4-methyl-tetrahydro-pyran-3-ylamino)-3-(1H-indol-2-yl)-propionic acid | Hexadecanoic acid, 2-hydroxy-1-(hydroxymethyl)ethyl ester |
| 11 | Lycopene | Octadecanoic acid, 2,3-dihydroxypropy ester |
| 12 | Hexadecanoic acid, 2-hydroxy-1-(hydro oxymethyl) ethyl ester | Methyl stearate |
| 13 | Bis(2-ethylhexyl) phthalate | Pyrrolo[1,2-a]pyrazine-1,4-dione, hexa hydro-3-(2-methylpropyl)- |
| 14 | Octocrylene 2-Propenoic acid, | Tetradecane |
| 15 | Octadecanoic acid, 2,3-dihydroxypropyl ester | Eicosane |
| 16 | Squalene e 2,6,10,14,18,22-Tetracosahexaene, | Heneicosane |
| 17 | Phenol, 2,4-bis (1,1-dimethyl ethyl)-, phosphite | |
| 18 | Tris (2,4-di-tert-butyl phenyl) phosphate | |
| 19 | Octahydro-2H-pyrido(1,2-a)pyrimidin-2-one | |
| 20 | Olean-18-ene | |
| 21 | l-Leucine | |
| 22 | L-Proline | |
| 23 | Ergotaman-3′,6′,18-trione |
Disclaimer/Publisher’s Note: The statements, opinions and data contained in all publications are solely those of the individual author(s) and contributor(s) and not of MDPI and/or the editor(s). MDPI and/or the editor(s) disclaim responsibility for any injury to people or property resulting from any ideas, methods, instructions or products referred to in the content. |
© 2024 by the authors. Licensee MDPI, Basel, Switzerland. This article is an open access article distributed under the terms and conditions of the Creative Commons Attribution (CC BY) license (https://creativecommons.org/licenses/by/4.0/).
Share and Cite
Sharma, N.; Koul, M.; Joshi, N.C.; Dufossé, L.; Mishra, A. Fungal-Bacterial Combinations in Plant Health under Stress: Physiological and Biochemical Characteristics of the Filamentous Fungus Serendipita indica and the Actinobacterium Zhihengliuella sp. ISTPL4 under In Vitro Arsenic Stress. Microorganisms 2024, 12, 405. https://doi.org/10.3390/microorganisms12020405
Sharma N, Koul M, Joshi NC, Dufossé L, Mishra A. Fungal-Bacterial Combinations in Plant Health under Stress: Physiological and Biochemical Characteristics of the Filamentous Fungus Serendipita indica and the Actinobacterium Zhihengliuella sp. ISTPL4 under In Vitro Arsenic Stress. Microorganisms. 2024; 12(2):405. https://doi.org/10.3390/microorganisms12020405
Chicago/Turabian StyleSharma, Neha, Monika Koul, Naveen Chandra Joshi, Laurent Dufossé, and Arti Mishra. 2024. "Fungal-Bacterial Combinations in Plant Health under Stress: Physiological and Biochemical Characteristics of the Filamentous Fungus Serendipita indica and the Actinobacterium Zhihengliuella sp. ISTPL4 under In Vitro Arsenic Stress" Microorganisms 12, no. 2: 405. https://doi.org/10.3390/microorganisms12020405
APA StyleSharma, N., Koul, M., Joshi, N. C., Dufossé, L., & Mishra, A. (2024). Fungal-Bacterial Combinations in Plant Health under Stress: Physiological and Biochemical Characteristics of the Filamentous Fungus Serendipita indica and the Actinobacterium Zhihengliuella sp. ISTPL4 under In Vitro Arsenic Stress. Microorganisms, 12(2), 405. https://doi.org/10.3390/microorganisms12020405







